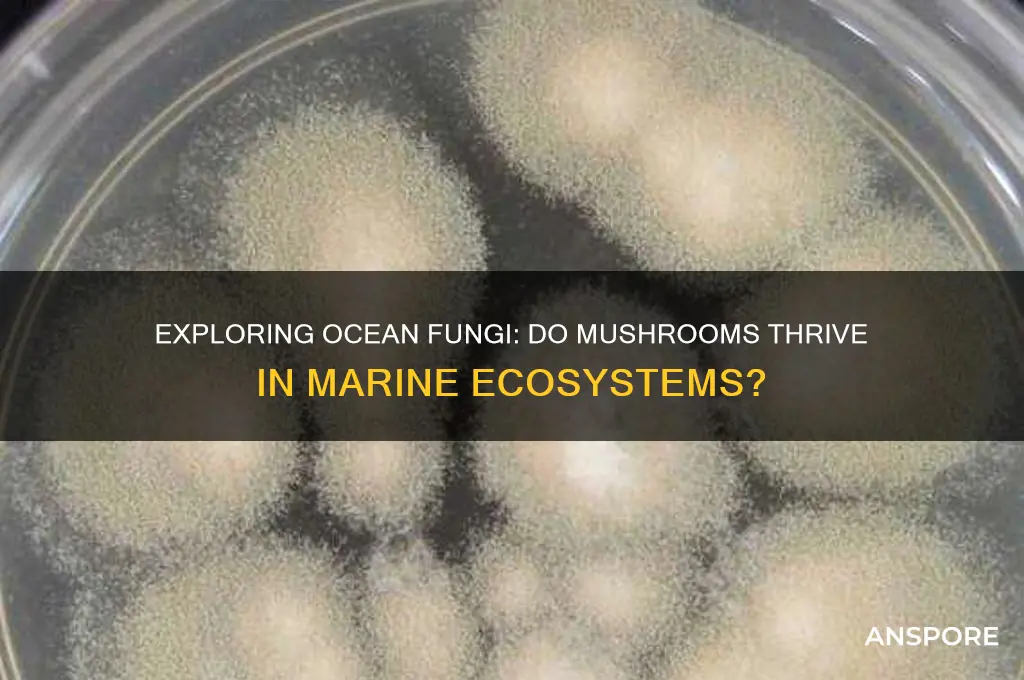
are there mushrooms in the ocean

The ocean, a vast and largely unexplored ecosystem, is home to an astonishing array of life forms, from microscopic plankton to colossal whales. While mushrooms are commonly associated with terrestrial environments, particularly forests and fields, the question of whether they exist in the ocean is both intriguing and complex. Marine fungi, including species that resemble mushrooms, have been discovered in various oceanic habitats, such as coral reefs, deep-sea sediments, and even within the tissues of marine organisms. These fungi play crucial roles in nutrient cycling, decomposition, and symbiotic relationships, challenging the traditional notion that mushrooms are exclusively land-dwelling organisms. Exploring the presence and function of mushrooms in the ocean not only expands our understanding of fungal diversity but also highlights the interconnectedness of life across different ecosystems.
| Characteristics | Values |
|---|---|
| Existence of Mushrooms in the Ocean | Yes, there are mushroom-like organisms in the ocean, but they are not true fungi like terrestrial mushrooms. |
| Types of Marine Mushroom-like Organisms | 1. Sponges (e.g., Clathrina clathrus, Tethya aurantium) 2. Stalked Ascidians (e.g., Styela clava) 3. Deep-sea Fungi (e.g., Lignincola species, recently discovered in ocean sediments) |
| Habitat | Shallow reefs, deep-sea sediments, hydrothermal vents, and cold seeps. |
| Appearance | Resemble terrestrial mushrooms in shape (stalk and cap-like structures) but are structurally and biologically distinct. |
| Biological Classification | Sponges: Animals (Porifera) Ascidians: Chordates (Tunicata) Deep-sea Fungi: Kingdom Fungi (true fungi). |
| Function | Sponges and ascidians: Filter feeders. Deep-sea fungi: Decomposers, breaking down organic matter in sediments. |
| Discovery of True Marine Fungi | Recent studies (e.g., 2020s) confirmed the presence of fungi in deep-sea sediments, challenging previous beliefs that fungi were absent in such environments. |
| Ecological Role | Contribute to nutrient cycling in marine ecosystems, particularly in deep-sea environments. |
| Research Status | Ongoing, with advancements in deep-sea exploration and molecular biology revealing new species and roles of marine fungi. |
Explore related products
$15.99 $19.99
$27.99 $29.99
What You'll Learn

Deep-sea mushroom species
The deep sea is a realm of mystery, with vast expanses of unexplored ecosystems. Among the unique organisms that inhabit this environment, deep-sea mushroom species have garnered attention from marine biologists and mycologists alike. Contrary to popular belief, mushrooms are not exclusive to terrestrial environments; several species have adapted to thrive in the ocean's depths. These deep-sea mushrooms, often referred to as "marine fungi," exhibit distinct characteristics that set them apart from their land-dwelling counterparts. They play crucial roles in the deep-sea ecosystem, contributing to nutrient cycling and forming symbiotic relationships with other marine organisms.
The anatomy of deep-sea mushroom species is adapted to their harsh habitat. Unlike terrestrial mushrooms, which rely on spores dispersed by air, marine fungi release spores into the water column. Their fruiting bodies are often smaller and more robust, designed to withstand strong ocean currents and pressure. Some species, like Juncigena, form symbiotic relationships with deep-sea sponges, providing nutrients in exchange for protection. This mutualism highlights the interconnectedness of deep-sea life and the importance of fungi in these ecosystems.
Studying deep-sea mushroom species presents significant challenges due to the inaccessibility of their habitats. Researchers use remotely operated vehicles (ROVs) and deep-sea submersibles to collect samples and observe these organisms in their natural environment. Advances in DNA sequencing have also allowed scientists to identify new species and understand their evolutionary relationships. Despite these efforts, much remains unknown about the diversity and ecological roles of deep-sea fungi, making them a frontier in marine biology.
Conservation of deep-sea mushroom species is critical, as their habitats are increasingly threatened by deep-sea mining, pollution, and climate change. Protecting these ecosystems is essential not only for preserving biodiversity but also for maintaining the health of the global ocean. As research continues, deep-sea mushrooms may reveal new insights into fungal biology, ecosystem dynamics, and even potential biotechnological applications. Their existence underscores the ocean's vast, untapped potential and the importance of exploring its depths.
Leftover Mushroom Agar: Can You Reuse It?
You may want to see also

Ocean fungi habitats
The ocean, often associated with vast expanses of water and marine life, is also home to a variety of fungi, including mushrooms. While mushrooms are commonly found in terrestrial environments, certain species have adapted to thrive in marine and coastal ecosystems, forming unique ocean fungi habitats. These habitats are primarily located in intertidal zones, deep-sea sediments, coral reefs, and even on marine organisms themselves. Fungi in these environments play crucial roles in nutrient cycling, decomposition, and symbiotic relationships with other marine life.
One of the most well-known ocean fungi habitats is the intertidal zone, where freshwater meets saltwater. This dynamic environment supports fungi that can tolerate fluctuating salinity levels. Species like *Lignincola laevis* are commonly found in driftwood along coastlines, breaking down lignin and cellulose in submerged wood. These fungi are essential for recycling organic matter, ensuring nutrients are returned to the marine ecosystem. Additionally, mangrove forests, which straddle land and sea, host fungi that help mangroves withstand harsh saline conditions and decompose fallen leaves and branches.
Deep-sea sediments also serve as ocean fungi habitats, though they are less explored. Fungi in these environments often form symbiotic relationships with other organisms or survive by decomposing organic material that sinks from surface waters. Recent studies have identified fungal species in hydrothermal vents and cold seeps, where they thrive in extreme conditions, including high pressure and low oxygen levels. These fungi contribute to the breakdown of complex organic compounds, supporting the unique microbial communities in these deep-sea ecosystems.
Coral reefs, known for their biodiversity, are another important ocean fungi habitat. Fungi in these environments often live in association with sponges, algae, and corals, forming mutualistic relationships. For example, some fungi protect corals from pathogens by producing antimicrobial compounds, while others help in nutrient uptake. However, fungal pathogens can also pose threats to coral health, particularly in stressed or polluted reef systems. Understanding these interactions is crucial for coral conservation efforts.
Lastly, marine animals themselves can act as ocean fungi habitats. Fungi have been found on the skin, gills, and intestines of various marine species, including fish, mollusks, and crustaceans. These fungi often play roles in maintaining host health by preventing colonization by harmful microorganisms. However, some can become opportunistic pathogens, particularly in immunocompromised hosts. Research into these fungal communities is still in its early stages, but it highlights the interconnectedness of marine life and fungi in ocean ecosystems.
In summary, ocean fungi habitats are diverse and widespread, ranging from coastal areas to the deep sea and even within marine organisms. These fungi are integral to marine ecosystems, contributing to decomposition, nutrient cycling, and symbiotic relationships. As research continues, our understanding of these unique habitats and their ecological roles will deepen, shedding light on the hidden fungal diversity beneath the waves.
Lion's Mane Mushroom: Diarrhea Side Effect?
You may want to see also

Marine mushroom discovery
The ocean, a vast and largely unexplored ecosystem, has long been a source of fascination for scientists and researchers. While mushrooms are commonly associated with terrestrial environments, recent discoveries have shed light on the existence of marine mushrooms, challenging our traditional understanding of fungal habitats. Marine mushroom discovery is a rapidly evolving field, with researchers uncovering new species and ecosystems that thrive in the unique conditions of the ocean. One of the key factors driving this research is the recognition that marine fungi play a crucial role in nutrient cycling, organic matter decomposition, and symbiotic relationships with other marine organisms.
One notable example of marine mushroom discovery is the identification of the species Halocyphina villosa, a fungus that thrives in the cold, dark waters of the deep sea. This mushroom forms symbiotic relationships with marine invertebrates, providing them with essential nutrients in exchange for protection and a stable substrate. Another remarkable find is the Psathyrella aquatica, a mushroom that grows entirely submerged in freshwater and marine environments, challenging the conventional notion that mushrooms require air to survive. These discoveries highlight the adaptability and diversity of fungal life in the ocean, underscoring the need for further research to explore the full extent of marine mushroom biodiversity.
The process of marine mushroom discovery involves a combination of field surveys, molecular analysis, and laboratory experiments. Researchers use scuba diving, remotely operated vehicles (ROVs), and submersibles to collect samples from hard-to-reach areas of the ocean. Advanced DNA sequencing techniques are then employed to identify and classify new species, often revealing unexpected phylogenetic relationships between marine and terrestrial fungi. Additionally, laboratory studies help elucidate the ecological roles of marine mushrooms, such as their involvement in bioremediation, where they break down pollutants like oil and plastics in marine environments.
Despite these advancements, marine mushroom discovery faces significant challenges, including the vastness of the ocean, the difficulty of accessing deep-sea habitats, and the lack of specialized tools for studying marine fungi. However, ongoing technological innovations, such as improved underwater imaging and sampling devices, are expanding our capabilities to explore and document these unique organisms. As our understanding of marine mushrooms grows, so too does the potential for applications in fields like medicine, biotechnology, and environmental conservation. The discovery of marine mushrooms not only enriches our knowledge of ocean biodiversity but also highlights the interconnectedness of life on Earth, both on land and beneath the waves.
Mushrooms: Superfood or Super-risk?
You may want to see also
Explore related products
$14.99

Underwater mushroom ecosystems
The concept of underwater mushroom ecosystems might seem unusual, but recent research has revealed that fungi, including mushroom-like organisms, do indeed exist in marine environments. These unique ecosystems are primarily found in deep-sea habitats, where sunlight is scarce, and pressure is extreme. Unlike their terrestrial counterparts, underwater mushrooms have adapted to thrive in these harsh conditions, often forming symbiotic relationships with other marine organisms. For instance, some fungi have been discovered living in association with sponges, corals, and even the roots of seagrasses, playing a crucial role in nutrient cycling and ecosystem health.
One of the most fascinating aspects of underwater mushroom ecosystems is their ability to decompose organic matter in an environment where decomposition processes are typically slow. Marine fungi, including those that form mushroom-like structures, secrete enzymes that break down complex organic compounds, such as lignin and cellulose, which are abundant in sunken wood and other marine debris. This decomposition process not only recycles nutrients back into the ecosystem but also supports a diverse array of marine life, from bacteria to larger invertebrates. The presence of these fungi highlights the interconnectedness of marine ecosystems and their reliance on microbial processes.
Another critical role of underwater mushroom ecosystems is their potential involvement in carbon sequestration. Marine fungi, particularly those associated with submerged wood and plant material, can store significant amounts of carbon in their biomass and the surrounding sediment. This process helps mitigate climate change by removing carbon dioxide from the atmosphere and ocean. Additionally, the mycelial networks formed by these fungi can stabilize sediments, preventing erosion and enhancing the overall health of coastal and deep-sea environments.
Despite their importance, underwater mushroom ecosystems remain understudied compared to terrestrial fungal communities. Advances in deep-sea exploration technology, such as remotely operated vehicles (ROVs) and submersibles, have begun to shed light on these hidden ecosystems. However, much work remains to fully understand their distribution, diversity, and ecological functions. Continued research is essential to uncover the full potential of underwater mushrooms, from their role in marine food webs to their applications in biotechnology and environmental conservation.
In conclusion, underwater mushroom ecosystems represent a fascinating and largely unexplored frontier in marine biology. Their ability to adapt to extreme conditions, decompose organic matter, and support marine life underscores their ecological significance. As we continue to explore the depths of the ocean, these fungal communities will undoubtedly reveal new insights into the complexity and resilience of life on Earth. Protecting these ecosystems is not only crucial for marine biodiversity but also for the health of our planet as a whole.
Mushroom Mystery: Are They Acidic or Alkaline?
You may want to see also

Ocean fungi research
The question of whether mushrooms exist in the ocean has intrigued scientists and mycologists alike, leading to a growing field of study known as ocean fungi research. While mushrooms are typically associated with terrestrial environments, recent discoveries have revealed a diverse array of fungal species thriving in marine ecosystems. These findings challenge traditional notions of fungal habitats and underscore the importance of exploring the ocean's fungal diversity. Ocean fungi research aims to uncover the roles these organisms play in marine food webs, nutrient cycling, and ecosystem health, as well as their potential applications in biotechnology and medicine.
One of the key focuses of ocean fungi research is identifying and classifying marine fungal species. Unlike their terrestrial counterparts, marine fungi often exhibit unique adaptations to survive in saltwater environments, such as specialized cell walls and osmotic regulation mechanisms. Researchers employ molecular techniques, including DNA sequencing and metagenomics, to catalog fungal species in various marine habitats, from shallow coastal waters to the deep sea. These efforts have led to the discovery of novel fungal taxa, including species that form symbiotic relationships with marine algae, sponges, and corals. Understanding the phylogenetic relationships and ecological roles of these fungi is crucial for comprehending marine biodiversity.
Another critical aspect of ocean fungi research is investigating the ecological functions of marine fungi. Fungi are known decomposers in terrestrial ecosystems, breaking down organic matter and recycling nutrients. In the ocean, fungi contribute to the degradation of complex organic materials, such as wood, algae, and animal remains, playing a vital role in the marine carbon cycle. Some marine fungi also form mutualistic associations with other organisms, enhancing nutrient uptake and resilience to environmental stressors. For example, fungi associated with coral reefs may help their hosts withstand rising ocean temperatures and acidification. Research in this area is essential for predicting how marine ecosystems will respond to climate change and other anthropogenic impacts.
Despite significant advancements, ocean fungi research faces challenges, including the vast and often inaccessible nature of marine habitats. Deep-sea environments, in particular, remain understudied due to technological and logistical constraints. Furthermore, the cultivation of marine fungi in laboratory settings can be difficult, as many species have specific growth requirements that are not yet fully understood. Collaborative efforts between mycologists, marine biologists, and technologists are essential to overcome these obstacles and expand our knowledge of ocean fungi. Continued investment in this field will not only deepen our understanding of marine ecosystems but also unlock new opportunities for innovation and conservation.
Mushrooms' Intriguing Reproduction: Secrets of Their Survival
You may want to see also
Frequently asked questions
Yes, there are mushroom-like organisms in the ocean, though they are not true mushrooms. These include marine fungi and fungus-like organisms adapted to aquatic environments.
Marine fungi, such as *Lulworthia uniseptata*, and fungus-like organisms like *Halosarpheia* are examples. They resemble mushrooms in structure but are distinct from terrestrial fungi.
Some marine fungi and fungus-like organisms do produce spores, but their reproductive methods are often adapted to survive in saltwater conditions.
Most ocean mushroom-like organisms are not edible and have no known culinary or commercial uses. They primarily play ecological roles in marine ecosystems.
These organisms have evolved specialized adaptations, such as osmotic regulation and salt-tolerant enzymes, to thrive in the high-salinity environment of the ocean.











































